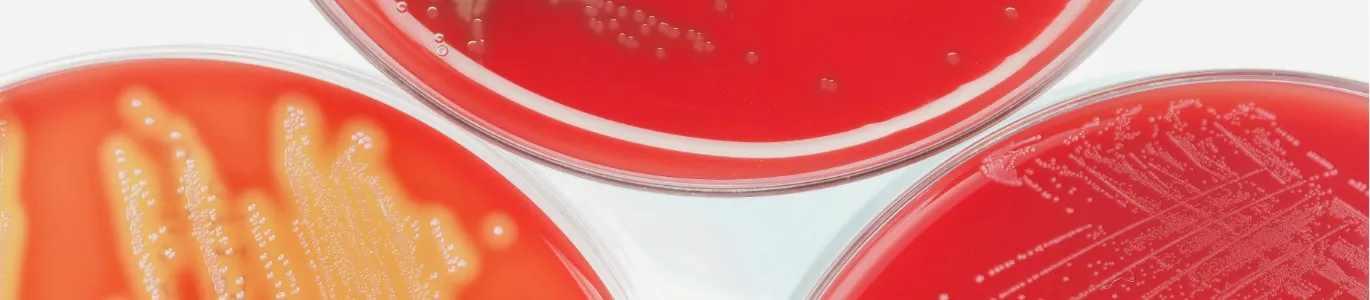

-
Telemedicina
-
Médicos a domicilio
-
Clínicas
-
Laboratorio Clinico
-
Estudios de gabinete
-
Seguros
-
Farmacias
-
Otros Servicios